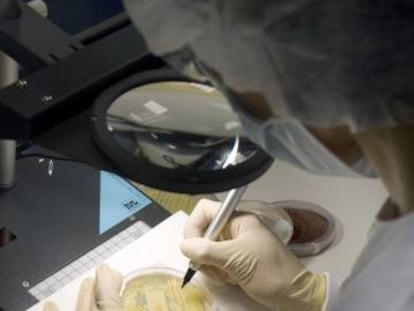

Condenada una pareja a ocho meses de cárcel por matar cinco gatos de su vecina
Los acusados envenenaron a otros tres gatos, que sobrevivieron tras ingerir bolitas de carne envenenada

Los acusados envenenaron a otros tres gatos, que sobrevivieron tras ingerir bolitas de carne envenenada

Un análisis de 522 ensayos confirma la utilidad de los 21 fármacos más comunes para tratar la depresión

Penti, Margarita Fuentes Pila y Manuel Penas, entre los clientes del exatleta Iván Hierro, condenado a seis meses por vender sustancias dopantes

La policía ha declarado que la sustancia no era peligrosa y trata el suceso como un delito de odio

Se hacen en pocos minutos y prometen soluciones milagrosas para los problemas digestivos, las migrañas o el adelgazamiento. Pero en realidad no son fiables y pueden derivar en dietas peligrosas para la salud.

Los arrestados utilizaban páginas web con apariencia de farmacias legales para distribuir 62 tipos de fármacos

Nevada y Nebraska deciden usar en próximas ejecuciones el poderoso y letal opiáceo

El rápido aumento de la prescripción de analgésicos derivados de la morfina alerta sobre el riesgo de sobremedicación

El padre Salvador Rangel cuenta en esta entrevista cómo es su trabajo en una de las zonas más violentas de México después de que asesinaran a balazos a dos de sus sacerdotes

Una investigación sobre el pian detecta casos de resistencias a la azitromicina , el antibiótico que elimina el microorganismo causante de esta enfermedad tropical

La supervivencia de algunas de estas startups depende de acuerdos con farmaceuticas que esperan incrementar la venta de sus fármacos

El autor alerta del hecho de que el omeprazol está sobreprescrito en nuestro país: se considera que del 54% al 69% de las prescripciones son inadecuadas

El hombre, de 40 años, dio positivo en anfetaminas y tiene antecedentes policiales

Construya una dieta rica en fitoquímicos para combatir los radicales libres. También si vive en una ciudad contaminada

En una carta abierta, el ciclista español de 29 años, expulsado del Lotto-Jumbo por utilizar somníferos no aprobados por el equipo, pide volver a competir

La companyia distribuïa el remei a tot Europa des de Barcelona

La farmacéutica IFC se convierte en CantabriaLabs y desarrolla un ambicioso plan de expansión

El hombre tomó la misma sustancia y se encuentra ingresado estable dentro de la gravedad

La tradicional creu lluminosa de l'establiment canvia l'hora i la temperatura per un missatge polític

Barry Sherman, fundador de la farmacéutica Apotex, y su esposa Honey fueron hallados sin vida el pasado 15 de diciembre en su residencia

Una web servirá para solicitar la evaluación e indemnización a los perjudicados por el fármaco

El rockero falleció por el efecto de una combinación de siete medicamentos
Las acciones de la compañía caen el 40% después de comunicar los resultados de Zepsyre

El Comisionado Nacional de Seguridad analiza la situación del país en el año con más asesinatos del sexenio de Enrique Peña Nieto

Intentar que en la farmacia se vendan tus productos y no los de la competencia hace que los laboratorios apuesten por algo que antes no necesitaban: la publicidad

Les peces de bijuteria contenien una toxina al·lucinògena que pot ser mortal

Mejorar la dieta, hacer ejercicio y tomar el sol son mejores pautas

Los médicos achacan el aumento del consumo de fármacos para el dolor agudo al envejecimiento poblacional

Els metges atribueixen l'augment del consum de fàrmacs destinats a pal·liar el dolor agut a l'envelliment de la població

El endulzante trehalosa contribuyó al auge de infecciones hospitalarias en Europa y EE UU, según un estudio

El consumo masivo de medicamentos y drogas acorta la esperanza de vida en Estados Unidos, merma el mercado laboral y obliga a las empresas a tomar medidas extraordinarias

La rana dardo dorada es el vertebrado más venenoso que existe

En España apenas aumenta el consumo de esta sustancia y no hay más muertes por esta causa. El año pasado falleció en todo Madrid una persona por sobredosis

La crisis de las drogas y los opiáceos es uno de los factores principales

Los investigadores que lo han estudiado dicen que, además, puede prevenir los defectos de nacimiento. ¿Cantos de sirena?

Solo la mitad de las personas infectadas con el VIH reciben tratamiento. Hacer llegar medicamentos a todos es una de las claves

La presidenta del grupo farmacéutico y miembro de la cuarta generación familiar, se enfrenta a la reestructuración de la empresa

Barry Sherman, fundador de la famarcéutica Apotex, y su esposa, Honey, estaban en el sótano de su mansión en venta

El Lotto-Jumbo holandés estudia rescindir el contrato del ciclista gaditano en una decisión que saca a la luz el problema del abuso de somníferos y tranquilizantes en el pelotón